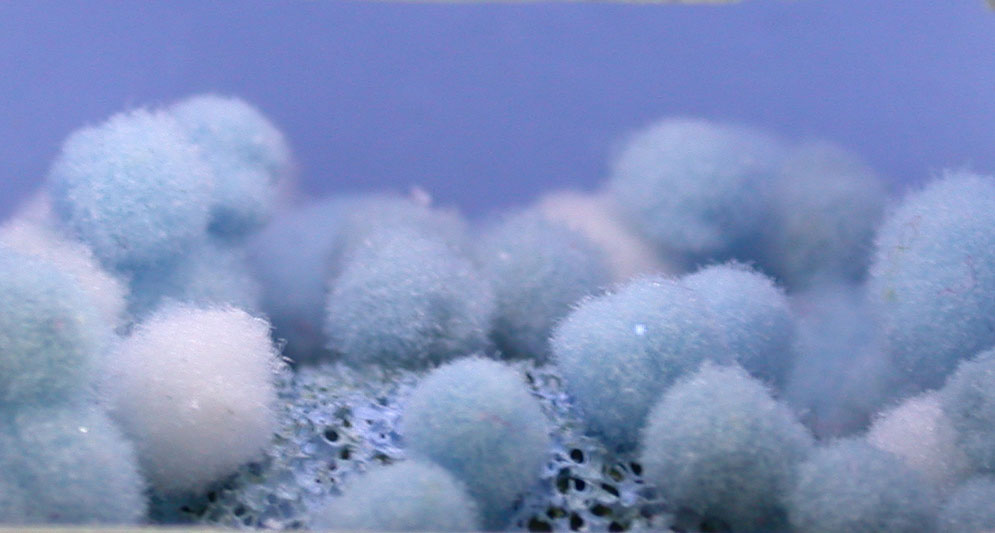

WORK | BIO | CONTACT
KATHERINE SHAUGHNESSY
Landescape #11: Bluewater
| Landescapes |

2"h x 2"d x 2"w, ceramic, plaster, paint & other materials, 2003
Collection of Tim Tokerud
Copyright Ⓒ 1998-2021 Katherine Shaughnessy